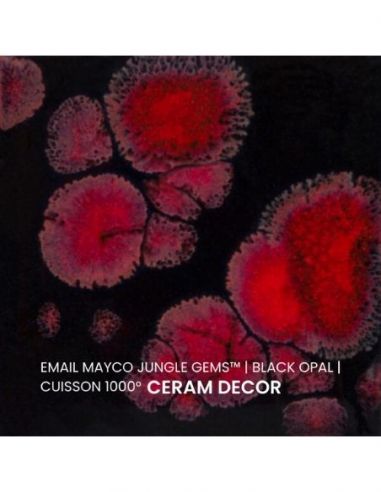
Email CG779 Black opal | MAYCO

Le produit est disponible
Le produit est disponible En cours de réapprovisionnement
En cours de réapprovisionnement Le produit n'est plus en stock
Le produit n'est plus en stock
Émail Mayco® fabriqué sans plomb et sont livrés liquides prêts à l'emploi.
L'émail black opal de la série "Jungle Gems" Mayco® se compose d'une couleur de fond et de cristaux brillants colorés. Il est non toxique, possède un temps de séchage rapide et stable, tout en donnant à votre pièce un résultat étonnant! Sa composition et son mode de fabrication lui assure un excellent nappage lors de la cuisson qui corrige éventuellement les défauts d'application. Il est très flexible et simple d'emploi. Chaque émaillage est différent, les cristaux s'étalent sur les pièces plates et coulent sur les pièces verticales. Ils peuvent être superposés ou mélangés pour donner des effets spéciaux.
Mode d'emploi :
- Remuez le pot énergiquement avant de l'utiliser. Appliquer ensuite votre émail sur un biscuit de faïence au pinceau en deux couches et re mélangez les cristaux pour l'application de la troisième couche. Appliquez les cristaux en les déposant sur la surface émaillée, évitez la partie proche de votre plaque de cuisson afin que l'émail et ses cristaux ne coulent dessus.
- Laissez les articles sécher complètement et faites cuire entre 1000°C et 1040°C. Plus la température sera élevée, meilleur sera le nappage et plus les contrastent apparaîtront sur les reliefs.
- Marque
- MAYCO
- Couleur
- Multi couleur
- Finition
- Brillant
- Type
- Liquide
- Plage de température
- 1000°C - 1040°C
- Série
- Jungle Gems
- Utilisation
- sur faïence
- Recommandations à usage alimentaire
- Nous vous conseillons de faire analyser ces objets par un organisme agréé afin de valider la conformité avec les normes actuelles.
-
Pas encore testé
-
Pas encore testé